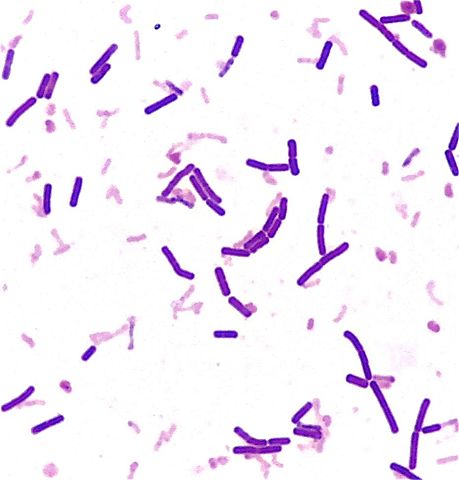
Tinción de Gram

-
Demostró que los gusanos encontrados en la carne podrida eran las larvas que provenían de los huevos que previamente habían depositado en la carne las moscas y no el producto de la generación espontánea.
-
Gracias a su mejoramiento del microscopio, descubrió los primeros microorganismos a cuales denominó animáculos a partir de la observación del agua de lluvia, mar, río y saliva.
-
Spallanzani dudaba de los resultados de los últimos experimentos que apoyaban la generación espontánea que habían sido realizados en 1748 por John Needham. Realizó una nueva serie de experimentos en los que hirvió entre 30 y 45 minutos frascos que contenían un caldo nutritivo. Algunos de los frascos estaban sellados y otros no. Spallanzani observó que en los frascos sellados no había microorganismos y demostró así que la generación espontánea no se producía.
-
C. Davaine descubrió con la ayuda de Pierre Rayer un microorganismo en la sangre de ovejas enfermas y moribundas el cual hoy se conoce como Bacillus anthracis (Anthrax) y acuñó el termino "bacteridios".
-
Pasteur fue un importante químico francés, que tuvo una enorme importancia en diversos campos de las ciencias especialmente en la microbiología. Su descubrimiento más reconocido es la pasteurización que permitió desarrollar la esterilización.
-
Realizó investigaciones con las cuales consiguió un medio sólido transparente para observar la morfología de las colonias microbianas.
-
El médico danés Christian Gram intentando aislar algunas bacterias de neumonía, se percató de que algunas bacterias retenían la violeta de genciana.
-
John Tyndall desarrolló el proceso de esterilización mediante calentamiento discontinuo.
-
Desarrolló el método de cultivo de enriquecimiento e investigó sobre las bacterias quimioautótrofas.
-
Incitó el uso de técnicas nuevas, incorporando indicadores de pH a la composición de ciertos medios con lo cual se podía observar la producción de ácidos en la fermentación en ciertos microorganismos.
-
Descubre los grupos sanguíneos humanos
-
Desarrolla el primer tratamiento con agentes quimioterapeuticos
-
Descubre el primer tipo de virus oncogénico
-
Descubren los virus bacterianos (bacteriófagos)
-
Vinogradski es conocido por conocer la quimioautotrofia, el proceso por el cual los organismos derivan energia de un número de compuestos diferentes inorgánicos, obteniendo carbono en la forma de dióxido de carbono.
-
Después de un tiempo de vacaciones, Alexander Fleming descubrió la penicilina, una sustancia natural anti-bacteriana.
-
Descubrimiento de la estreptomicina
-
Descubren la conjugación bacteriana
-
Demuestra bioquímicamente la transmisión genética mediante DNA en escherichia coli
-
Publican el modelo del DNA e identifican una estructura quimicamante definida (la doble hélice)
-
Descubre microorganismos responsables de ciertas enfermedades degenerativas del sistema nervioso central (priones)
Looking for a timeline maker?
Create timelines for projects, roadmaps, history, lessons, legal cases, and stories with Timetoast. Timetoast is a timeline maker for work, school, research, and stories.